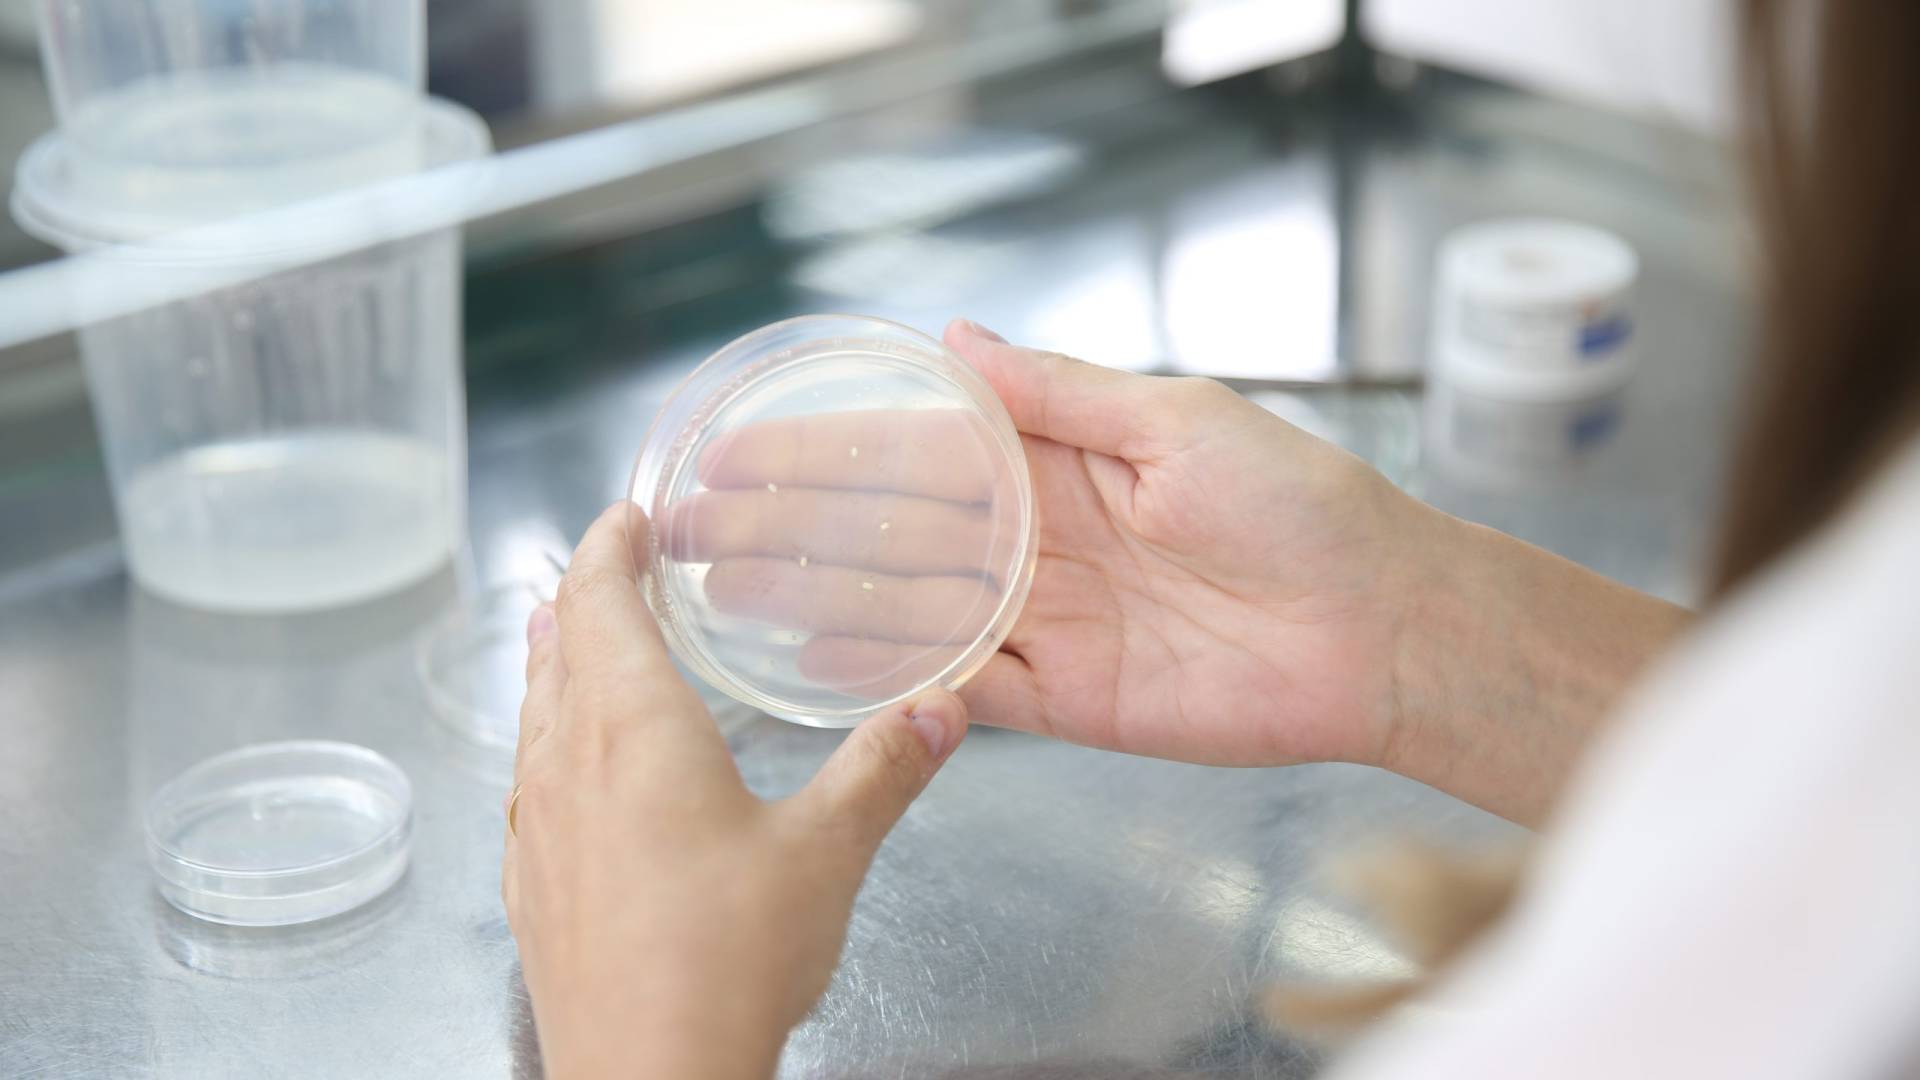

Economia
Milho mais resistente ao calor: pesquisa usa bactéria para enfrentar os impactos das mudanças climáticas
Em Campinas (SP), uma pesquisa inovadora da Empresa Brasileira de Pesquisa Agropecuária (Embrapa) está criando…
Prazo para resgatar recursos “Esquecidos” pelo Banco Central termina, mas ainda há chance de recurso
O prazo oficial para resgatar os recursos “esquecidos” nos bancos terminou em 16 de outubro,…
Retiradas menores da poupança em 2024 refletem melhora econômica
As retiradas de recursos das cadernetas de poupança no Brasil em 2024 foram menores do…
Ibovespa registra mais pregões negativos do que positivos em 2024, primeira vez desde 2015
O Ibovespa, principal índice da bolsa de valores brasileira, encerrou 2024 com mais pregões negativos…
Dólar opera em baixa enquanto investidores aguardam novos dados econômicos
Foto: Karolina Grabowska/Pexels O dólar segue em queda nesta terça-feira (7), sendo negociado a R$…
Gol, Uno e Palio lideram vendas de carros usados em 2024, com maior volume de vendas desde 2011
Em 2024, o mercado de veículos usados no Brasil alcançou um impressionante número de 15.777.594…
Dólar Opera em Baixa e Expectativas do Mercado se Voltam para Menos Tarifas de Importação nos EUA
O dólar iniciou a semana em baixa nesta segunda-feira (6), cotado a R$ 6,10 por…
Aposentadoria pelo INSS: Como calcular o benefício e o tempo de contribuição em 2025
A reforma da Previdência, aprovada em 2019, trouxe mudanças significativas nas regras de aposentadoria, afetando…
Aumento nos preços dos combustíveis em 2024: Gasolina, diesel e etanol registram alta nos postos
Em 2024, os preços dos combustíveis no Brasil sofreram variações significativas, com aumento nos valores…
Reajuste do salário mínimo: Piso nacional sobe 7,5% em 2025
O presidente Luiz Inácio Lula da Silva sancionou, no final de 2024, o reajuste do…